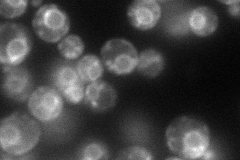
YAL026C
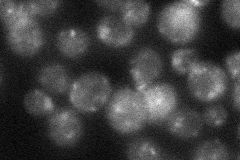
YAL026C
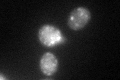
YAL026C

View description
Aminophospholipid translocase (flippase) that maintains membrane lipid asymmetry in post-Golgi secretory vesicles; contributes to clathrin-coated vesicle formation and endocytosis; mutations in human homolog ATP8B1 result in liver disease
Localization:
Intensity:
Fold change:
Significance:
-
C’ GFP library in SD

punctate35.98 -
N' NOP1pr-GFP in SD
ER,punctate87.2838 -
N' TEF2pr-mCherry in SD

ER94.0487 -
N' NATIVEpr-GFP in SD
punctate29.2221 -
N' TEF2pr-VC and Cyto-VN in SD

ER,punctate40.8051 -
C’ GFP library in SD+DTT
punctate46.461.29No -
C’ GFP library in SD+H2O2

punctate40.991.13No -
C’ GFP library in Starvation Media

punctate32.890.91No -
C’ GFP library on the background of Pup2-DaMP

punctate -
C’ GFP library on the background of CCT mutant

punctate29.63160.823449No
